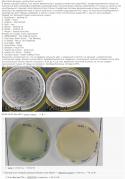
17205_lan.

Upload Pictures - PictureShack Image Hosting
Picture Gallery - page 46130
Pictures in Gallery: 1802681
<< Previous Next >>
1 - 30 | 31 - 60 | 61 - 90 | ... | 1383811 - 1383840 | 1383841 - 1383870 | 1383871 - 1383900 | 1383901 - 1383930 | 1383931 - 1383960 | ... | 1802611 - 1802640 | 1802641 - 1802670 | 1802671 - 1802681
 |
 |
 |
 |
 |
 |
 |
 |
 |
 |
 |
 |
 |
 |
 |
 |
 |
 |
 |
 |
 |
 |
 |
 |
 |
 |
 |
 |
 |
|
1 - 30 | 31 - 60 | 61 - 90 | ... | 1383811 - 1383840 | 1383841 - 1383870 | 1383871 - 1383900 | 1383901 - 1383930 | 1383931 - 1383960 | ... | 1802611 - 1802640 | 1802641 - 1802670 | 1802671 - 1802681
<< Previous Next >>